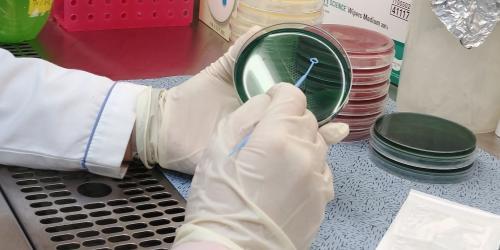

|
 2026.02.19(목) 21:55 2026.02.19(목) 21:55 |
|
|

 |
|
 |
|
 |
|

 |
||||||||||||||||||||||||
 |
사명:(주)신동아방송 / 등록번호:서울 아02766 / 최초등록일:2013 년 5월 26일 / 제호:신동아방송·SDATV / 발행인·편집인:이신동
본사:서울특별시 서초구 강남대로2길 70 (양재동) / 홈페이지:www.sdatv-su.co.kr
전화:(02)846-9300 / 팩스:(0505)300-8014 / 이메일:sdatv@sdatv.co.kr / 개인정보취급방침·청소년보호책임자:이신동
(주)신동아방송을 통해 제공되는 모든 콘텐츠(기사 및 사진)는 무단 사용, 복사, 배포 시 저작권법에 저해되며 법적 제재를 받을 수 있습니다. | ||